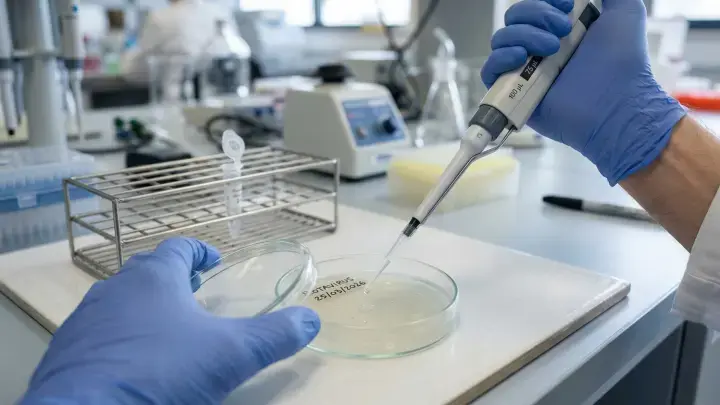
Тихий убийца: подмосковный врач предупредила об опасности ВПЧ

Тихий убийца: подмосковный врач предупредила об опасности ВПЧ
Бесплатно и жизненно важно: в России ввели новые правила проверки на вирус папилломы человека.
Вирус папилломы человека (ВПЧ) считается одной из самых коварных инфекций современности: он годами живёт в организме, никак не выдавая своего присутствия, пока не нанесёт сокрушительный удар по здоровью. О том, почему эту «тихую» угрозу нельзя игнорировать, в беседе с «Радио 1» рассказала заместитель главного врача Дубненской больницы Светлана Яхина.
Главная опасность ВПЧ заключается в его скрытности. По словам специалиста, вирус не имеет специфических симптомов и обнаруживается только прицельным обследованием. При этом штаммы вируса ведут себя по-разному. Одни вызывают лишь безобидные на первый взгляд бородавки и папилломы, которые передаются даже бытовым путём через микротрещины на коже. Другие же — высокоонкогенные типы (16, 18, 31 и 45) — годами подтачивают репродуктивную систему, становясь главной причиной развития рака шейки матки у женщин.
Статистика неумолима: по разным данным, носителями различных типов ВПЧ являются более 50% населения планеты. При этом опасные онкогенные штаммы встречаются примерно у каждого пятого. Основной путь их передачи — половой, а в группе риска находятся все сексуально активные люди.
Хорошая новость в том, что с 2026 года жительницы Московской области в возрасте от 18 до 49 лет могут бесплатно пройти скрининг на 14 самых опасных типов ВПЧ. Это исследование официально включено в программу репродуктивной диспансеризации по полису ОМС. Женщинам старше 50 лет тест также доступен бесплатно — его проводят во время планового визита в женскую консультацию.
Врачи подчёркивают: выявление вируса — это не приговор, а руководство к действию. Своевременный контроль позволяет медикам скорректировать тактику наблюдения и предотвратить развитие онкологии на самых ранних стадиях. Кроме того, эксперты напоминают о важности вакцинации. Прививка эффективна как для женщин, так и для мужчин, причём делать её можно не только подросткам, но и взрослым людям, уже начавшим половую жизнь.